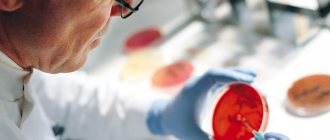

Главная » Муковисцидоз »
- Препараты
Муковисцидоз – заболевание, которое обусловлено наличием генетических особенностей. Оно проявляется у людей, если в близком кругу родственников также есть больные этим недугом.
Происходят поражения органов пищеварения, для которых характерны свои симптомы и признаки. Болезнь не поддается лечению и принимает со временем хроническую форму.
Механизм возникновения болезни
Муковисцидоз у взрослых – это патологическое состояние, которое возникает из-за генной мутации. В этом случае изменен ген, который находится в седьмой хромосоме. Болезнь передается только в том случае, если носителями такого гена являются оба родителя, при этом риск заболеть составляет 25%.
Несмотря на определенные условия, такое заболевание встречается в медицинской практике довольно часто. Это объясняется тем, что носителем такого гена является каждый 20-й житель.
Муковисцидоз проявляется уже в раннем детстве, но при легком течении болезни правильный диагноз ставится не сразу.
Что такое муковисцидоз у взрослых
Муковисцидоз – генетическое заболевание, вызванное аномалией гена седьмой хромосомы. Болезнь сопровождается поражением органов респираторного тракта, пищеварительной системы и желез секреции. Патология быстро прогрессирует, провоцируя развитие необратимых осложнений.
Муковисцидоз передаётся от родителей детям при условии, что оба партнёра являются носителями мутировавшего гена, при этом возможность заболеть не превышает 25%.
Формы заболевания
Форма заболевания напрямую зависит от наиболее пораженной зоны. Например, если в большей степени поражена легочная ткань, то говорят о муковисцидозе легких, но это совсем не означает, что другие органы совсем не подвержены этой патологии. Стоит помнить, что при любой форме болезни патологические изменения затрагивают абсолютно все важные органы.
В медицинской практике выделяют такие формы протекания муковисцидоза:
- легочную;
- кишечную;
- смешанную.
Каждая из форм муковисцидоза имеет определенные симптомы и особенности терапии. Но в любом случае очень важна ранняя диагностика и лечение, чтобы облегчить состояние больного.
При постоянном лечении и отсутствии осложнений больные муковисцидозом доживают только до 40 лет.
Лечение муковисцидоза
Важно! Больной должен настроиться на длительный или пожизненный курс приема лекарственных препаратов. Это позволит остановить прогрессирование заболевания.
В лечении муковисцидоза врачи придерживаются следующей тактики:
- Назначают лекарственные препараты и процедуры, которые способствуют очищению бронхов от слизи.
- Устраняют или не дают размножаться в организме пациента болезнетворных бактерий и микроорганизмов.
- Врач назначает препараты, которые будут способствовать усилению иммунной системы. Для этого прописывают не только препараты, но и подбирают специальную диету.
- С пациентом проводят работу психологи, чтобы стабилизировать психическое состояние больного и научить его избегать стрессовых ситуаций.
Также подбор лекарственных препаратов подбирают с учетом тяжести заболевания. Лечение во время приступов, в период обострения болезни или в период ремиссии в некоторой степени отличается назначением медикаментов.
Легочная форма
Эта форма заболевания характеризуется появлением сильного кашля, который нередко заканчивается рвотой. Если болезнь начинается с раннего возраста, а у многих людей первые симптомы наблюдаются с рождения, то у взрослого кашель приобретает хроническую форму.
Основными признаками легочной формы заболевания являются такие нарушения здоровья:
- бледность кожных покровов и сероватый оттенок некоторых участков кожи;
- слабость и апатичность;
- выраженное снижение веса при полноценном питании;
- надрывный кашель, который чем-то напоминает коклюшный.
При кашле отходит вязкая мокрота, часто со слизью и частицами гноя. Гнойное содержимое всегда свидетельствует о присоединении бактериальной инфекции. Вязкая мокрота может привести к мукостазу, а также к полной закупорке бронхов. Благодаря этому развивается тяжелая пневмония, которая плохо поддается лечению. В этом случае могут добавиться другие симптомы заболевания:
- синюшность кожных покровов;
- грудина начинает выпирать вперед и напоминает бочку;
- даже в состоянии полного покоя наблюдается одышка;
- отсутствует аппетит и понижается вес;
- фаланги на пальцах заметно искривляются.
При продолжительном муковисцидозе происходят изменения в носоглотке. За счет этого могут развиться сопутствующие заболевания – аденоиды, полипы, хронический тонзиллит и синуситы.
Больные муковисцидозом женщины могут иметь детей, но часто при родах развивается легочная недостаточность. Больные этим недугом мужчины бесплодны, но продолжительность жизни у них выше.
Причины и происхождение муковисцидоза
Слизь, которая находится в лёгких, задерживает бактерии внутри и препятствует нормальному дыханию. Таким образом, в организме здорового человека постоянно образуется инфекция, которая приводит к повреждению лёгких, может возникнуть дыхательная недостаточность. Если слизь располагается в поджелудочной железе, то она не даёт формироваться пищеварительным ферментам, которые разрушают пищу в желудке. Поэтому не происходит поглощения жизненно важных питательных элементов организмом.
Первые симптомы заболевания были описаны в сороковых годах XX века. Из названия следует, что «мукас» — греческий корень, который значит «слизь», «вязкус» — это клей. Если сложить две частицы вместе, то болезнь можно перевести дословно как «слизистый секрет». Он выделяется наружу разными секрециями организма. Вещество обладает высокой вязкостью.
Врачами точно установлено, что заболевание муковисцидоз является генетическим. Болезнь передается по наследству от родителей. Муковисцидоз незаразный, даже если у человека вредные условия работы и сложный образ жизни, то заболеть не получится. Врачами выявлено, что заболевание не связано с полом человека. Муковисцидоз может быть как у мужчин, так и у женщин.
Вид передачи заболевания считается рецессивным, но не основным. Заболевание зашифровано на генетическом уровне. Если нездоровые гены есть только у одного из родителей, то, скорее всего, ребёнок будет здоров. По статистике четверть наследников здоровые, а половина содержит в своём организме ген муковисцидоза, но он располагается на хромосомном уровне.
Приблизительно у 6% взрослого населения Земли в организме есть материал этого гена. Если ребёнок появляется от родителей, которые обладают искажённой хромосомной информацией, то только в четверти случаев заболевание передается малышу. Именно этот тип передачи заболевания называется рецессивным.
Болезнь не связана с полом человека, потому что материал не находится в половых генах. Ежегодно рождается равное количество заболевших как мальчиков, так и девочек. На пол человека никакие дополнительные факторы не оказывают влияния. Неважно, как проходила беременность, насколько здорова мать или отец, какие у них условия проживания. Это заболевание передается только генетически. В девяностых годах были отмечены основные признаки болезни:
- Врачами точно установлено, что дефектный ген располагается в 7 хромосоме.
- Из-за мутации случается нарушение белковой субстанции, поэтому возникает вязкость секрета, изменяются его химические и физические свойства.
- Ещё не до конца выяснено, почему появляется мутация и как она фиксируется в генетическом плане.
Болезнь органов пищеварения и дыхания
Эндокринные железы — это органы, снабжающие кровь биологически функциональными элементами, которые называются гормонами. Благодаря им происходит регулирование физиологических процессов. Заболевание эндокринных желез — это симптомы муковисцидоза. Органы в человеческом организме, которые отвечают за производство связи, следующие:
- Пищеварение.
- Дыхание.
- Вывод вредных токсинов.
К этим органам причисляются слюнные железы, поджелудочная железа. Они отвечают за выработку бронхиального секрета. У взрослых симптомы муковисцидоза заключаются в патологической густоте физиологически необходимого слизистого слоя. В просвете бронхиального дерева образуется плотная слизь. Поэтому из процесса жизнедеятельности оказываются исключены органы дыхания. Организм перестает получать нужный кислород, поэтому образуется ателектаз легких.
Из-за муковисцидоза в печени формируется и искажается жировой и белковый слой, происходит застой желчи, в результате больной страдает из-за цирроза печени. У заболевания муковисцидоз есть и иное название — это кистозный фиброз.
Если у новорождённого ребёнка отмечена кишечная непроходимость, то в первую очередь страдает кишечник. Это происходит из-за отечности подслизистого слоя кишки. Заболевание почти всегда сопровождается другими нарушениями ЖКТ.
Симптомы кистозного фиброза
Симптомы заболевания обнаруживаются в раннем детстве. Диагностика муковисцидоза поможет выявить пути решения, провести эффективное лечение. Если на раннем этапе жизни симптомы не обнаружены, то они могут возникнуть в более позднем возрасте. Как определить, что у человека кистозный фиброз:
- Выпадение прямой кишки.
- Деформация ногтей.
- В носу может появиться доброкачественное новообразование.
- Пациент часто страдает бронхитом или пневмонией, у него нарушаются органы дыхания.
- Происходит выдох через рот, бывают частые приступы кашля, при этом происходит значительное отделение мокроты.
- Дыхание может быть со свистом или хрипом.
- У пациента часто диагностируется диспепсия — это нарушение функционирования желудка.
- У человека часто бывает нездоровая худоба, хотя он хорошо питается.
- Кожа у заболевшего муковисцидозом солоноватая.
Хронические формы
У заболевания есть клинические виды, в зависимости от протекания различают кишечную, атипичную, мекониевую непроходимость, бронхолегочную, легочную формы. Заболевание имеет генетическую форму и тесно связано с каждодневными физиологическими процессами, протекающими в организме. Обычно клинические проявления муковисцидоза выявляются у новорожденного ребенка. Известны случаи, когда заболевание обнаруживалось при внутриутробном развитии плода. У новорожденных детей часто диагностируется мекониевая непроходимость.
Меконием зовется первородный кал. Это первые испражнения новорожденного малыша. Если ребёнок здоров, то испражнения выделяются в первые сутки. При заболевании задержка каловых масс сопряжена с отсутствием фермента поджелудочной железы, который называется трипсин. Кишечник не образует этот элемент, в результате каловые массы застаиваются. Это происходит в ободочной и слепой кишке.
При прогрессировании заболевания обнаруживаются симптомы:
- Ребёнок сначала срыгивает, а затем его тошнит.
- У малыша ярко выраженное вздутие живота.
- Кроха беспокоен, часто и много плачет.
При осмотре врач может заметить усиленный сосудистый рисунок на животике, при простукивании обнаруживается барабанный отзвук. Настроение ребенка часто меняется: сначала он беспокойный, а затем вялый. У него отсутствует необходимая двигательная активность. Кожный покров бледный и сухой. Из-за того, что у ребёнка не происходит вовремя выделение каловых масс, наступает отравление организма продуктами внутреннего распада. При прослушивании сердца выявляются следующие симптомы:
- Не прослушивается перистальтическое движение кишечника.
- Дыхание у новорожденного учащенное.
- Обнаруживается синусовая тахикардия сердца.
Если новорожденный болен муковисцидозом, то у него диагностируется вздутие петель тонкого кишечника, а также резко спадает кишечный отдел в нижней части животика. Из-за того, что ребёнок слишком маленький, его состояние стремительно ухудшается. У малыша может в качестве осложнения возникнуть перитонит.
Он происходит из-за разрыва стенок кишки. А также осложнение происходит в виде пневмонии, у новорожденных она случается затяжной и в тяжёлой форме.
Недостаточность дыхания
Если у пациента легочная форма протекания заболевания, то у него отмечается бледная кожа, маленький вес. Но при этом аппетит у человека хороший. Если есть заболевание у новорожденного, то уже в первые дни жизни у него появляется кашель, интенсивность которого постоянно нарастает. Начинаются коклюшообразные приступы, которые называются реприза. Как происходит поражение лёгких:
- Вязкая и густая слизь заполняет небольшие просветы в бронхах.
- Формируется эмфизематозная область.
- Аномалия всегда двухсторонняя, это считается явным диагностическим симптомом.
- Обычно поражаются ткани легких, поэтому у заболевшего часто обнаруживается пневмония.
В легких пациента образуется слизь, которая является отличной средой для развития микроорганизмов, способных возбудить пневмонию. Мокрота впоследствии становится гнойной и слизистой, из неё выделяется стрептококк, патогенные микроорганизмы и стафилококк. Воспаление лёгких происходит в сложной и тяжёлой форме, обычно вследствие муковисцидоза провоцируются следующие осложнения:
- Пневмосклероз.
- Абсцессы.
- Сердечная недостаточность.
- Пневмоторакс.
- Лёгочная недостаточность.
Когда врачом прослушиваются легкие, то дифференцируются влажные хрипы. Звук над легкими обладает коробочным «эхом». Кожный покров у пациента бледный, при этом кожа сухая.
При доброкачественном протекании заболевания признаки болезни возникают только у взрослого человека. В это время организм вырабатывает механизмы компенсации. Симптомы постепенно нарастают, развивается хроническая пневмония, а затем диагностируется легочная недостаточность. Постепенно появляется бронхит с переходом в пневмосклероз.
При муковисцидозе не остаются без участия и верхние дыхательные пути. Вдобавок к заболеванию начинают образовываться аденоиды, придатки в пазухах и разрастание слизистой носа. У человека может быть обнаружен хронический тонзиллит. Заболевание не проходит незамеченным, внешний вид пациента меняется:
- Верхние и нижние конечности слишком худые.
- Масса тела постоянно снижается, несмотря на хороший аппетит.
- На нижних конечностях пальцев образуются барабанные палочки.
- Грудная клетка приобретает бочкообразный вид.
- При спокойном состоянии у человека возникает одышка.
- Кожа может приобрести синюшный оттенок.
- Кожный покров бледный.
В случае заболевания исследование выявит в просветах мелких бронхов густую слизь. Далее врачи проведут рентгенологическое исследование, где обычно диагностируется снижение ответвлений небольших бронхов.
Признаки кишечной формы
У здорового человека пищеварение проходит нормально благодаря выделению секретных компонентов, необходимых для этого процесса. У пациентов, больных муковисцидозом, выявляется пищеварительная недостаточность. Это происходит из-за минимальной выработки нужных жидкостей.
Симптомы заболевания возникают, когда ребёнок перестаёт употреблять только грудное молоко, его рацион становится разнообразным. В этом случае переваривание пищи становится более сложным, еда не продвигается по ЖКТ. Далее происходят активные гнилостные процессы.
Внешне заболевание проявляется вздутием живота и учащенным стулом. При этом аппетит у ребёнка не понижается, он потребляет большее количество пищи, чем здоровый малыш. Но прибавка в весе не происходит, при этом мышечный тонус понижен, кожа неупругая и дряблая. У заболевшего муковисцидозом выделяется минимальное количество слюны, поэтому пища запивается обильным количеством жидкости. Сухую еду становится очень трудно пережевывать. У поджелудочной железы не хватает нужного секрета, поэтому у ребёнка часто диагностируется сахарный диабет, язвенное заболевание желудка и аномалии пищеварительного тракта.
Нужные для жизнедеятельности вещества желудком не усваиваются, поэтому организм ощущает нехватку витаминов. У пациента может развиться гиповитаминоз. У грудных детей из-за недостатка белков в плазме наблюдается отечность. А также страдает печень, обнаруживается большое скопление желчи, что приводит к формированию холестаза. Внешне это заболевание характеризуется увеличением размера печени, сухостью кожного покрова, кожа приобретает желтоватый оттенок.
Смешанный вид заболевания
Эта форма причисляется к наиболее сложным видам. Уже с первых дней у новорожденного формируются признаки кишечной и легочной формы муковисцидоза:
- Пищеварительное нарушение и вздутие живота.
- Сильный кашель.
- Воспаление бронхов, легких.
- Гипотрофия.
Смешанные формы заболевания напрямую связаны с возрастом пациента. От этого болезни имеют более выраженный характер и злокачественность. Чем меньше возраст у ребёнка, тем хуже прогноз для купирования признаков заболевания.
Кишечная форма
Эта форма болезни характеризуется секреторной недостаточностью желудочно-кишечного тракта. В кишечнике наблюдаются застойные явления, что сопровождается излишним выделением газов и как следствие вздутием живота. При кишечной форме наблюдается такая симптоматика:
- частые позывы в туалет;
- сухость слизистой оболочки ротовой полости;
- сниженный тонус мышц;
- гипотрофия, которая всегда приводит к понижению веса;
- полигиповитаминоз;
- частая боль в области живота, под правым ребром и в мышцах.
При такой форме заболевания часты различные осложнения, которые проявляются такими патологиями:
- язвенные болезни;
- хронический пиелонефрит;
- дисахаридазная недостаточность;
- мочекаменная болезнь;
- полная или частичная непроходимость кишечника.
Иногда на фоне муковисцидоза может развиться билиарный цирроз, при котором наблюдается сильное чувство жжения кожи и ее выраженная желтушность.
Кишечная форма муковисцидоза считается очень тяжелой и плохо поддается лечению.
Симптомы муковисцидоза
Специалисты выделяют несколько форм заболевания: кишечную, легочную и смешанную.
К основным симптомам заболевания обычно относят:
- отсутствие аппетита, крики и громкий плач у грудничков и новорожденных;
- вздутие живота;
- ощущение сухости во рту.
Симптомы муковисцидоза зависят от формы болезни. Муковисцидоз легких сильно снижает иммунитет, а поскольку слизистые пробки легко поражаются бактериями стафилококка или синегнойной палочки, люди постоянно страдают от повторяющихся бронхитов и пневмоний.
Основные признаки муковисцидоза легких3:
- частые респираторно-вирусные заболевания;
- постоянный приступообразный кашель с густой и плохо отделяемой мокротой;
- склонность к воспалению легких и бронхитам на фоне острых респираторных вирусных инфекций;
- жесткое дыхание, появления свистящих хрипов при простудах и вирусных заболеваниях;
- появление одышки, признаков гипоксии;
- снижение веса, авитаминозы;
- изменение формы грудной клетки, которая приобретает вид лодочного киля, может становиться бочкообразной;
- ногтевые пластины, кончики пальцев приобретают вид барабанных палочек.
Кишечная форма муковисцидоза характеризуется ферментной недостаточностью, нарушением всасывания полезных веществ в кишечнике. В результате нехватки ферментов стул становится «жирным», могут активно размножаться бактерии, в результате чего накапливаются газы, что приводит к выраженному метеоризму. Стул учащается, а объем каловых масс может в несколько раз превышать возрастную норму.
У детей кишечная форма муковисцидоза протекает с повышенной вязкостью слюны и сильной жаждой. Аппетит может быть снижен из-за нарушения пищеварения, постоянных болей в животе и метеоризма3. С первых дней жизни ребенок может страдать кишечной непроходимостью, которая обусловлена нехваткой фермента трипсина, отвечающего за расщепление белков. В результате в тонком кишечнике происходит накопление мекония — плотной, густой массы темно-коричневого цвета. У ребенка появляются запоры и частые срыгивания, возможно возникновение рвоты. Помимо симптомов со стороны желудочно-кишечного тракта (ЖКТ) заболевание может сказываться на общем состоянии организма, поскольку качественное питание оказывает прямое влияние на развитие ребенка. Из-за нехватки полезных веществ могут появляться слабость, ломкость костей, ухудшаться состояние кожи, ногтей, волос.
Смешанная форма заболевания характеризуется сочетанием поражения кишечника и бронхолегочной системы. Это проявляется и в симптомах: люди со смешанной формой муковисцидоза страдают от частых вирусных заболеваний, затяжного кашля и одновременно от нарушения пищеварения, метеоризма.
Независимо от формы болезни одним из частых симптомов муковисцидоза является соленый вкус кожи больного. Это объясняется повышенным содержанием хлоридов в поте и на протяжении долгого времени являлось ключевым признаком для постановки диагноза.
Смешанная форма
Самый плохой прогноз в том случае, если муковисцидоз протекает в смешанной форме. Тогда заметны все симптомы легочной и кишечной формы. Выделяют 4 стадии заболевания этой формы, причем степень выраженности симптомов в каждом случае разная:
- Непродуктивный и сухой кашель, который не вызывает отхождения мокроты. Одышка бывает только после сильных физических нагрузок. Такая стадия болезни может продолжаться до 10 лет.
- Развивается хронический бронхит, при кашле отходит большое количество вязкой мокроты. При напряжении появляется сильная одышка. Фаланги пальцев заметно искривляются. Такая стадия болезни может продолжаться от 2 до 15 лет.
- На данной стадии бронхолегочный процесс начинает прогрессировать и давать осложнения. При этом дыхательная и сердечная недостаточность становятся хорошо заметными. Подобная стадия продолжается от 3 до 5 лет;
- Последняя стадия характеризуется тем, что сердечная и дыхательная недостаточность переходят в тяжелую форму. Такое состояние у человека продолжается несколько месяцев и заканчивается смертью.
Чем раньше начато лечение, тем благоприятнее прогноз. Муковисцидоз, который развивается у взрослых людей, часто хорошо поддается терапии. Главное, не пропустить начало заболевания.
Иногда заболевание протекает в скрытой форме, в таком случае выявить изменения можно посредством рентгенографии.
Диагностика
Диагностика муковисцидоза производится путем потовой пробы (анализ на муковисцидоз), где отмечается аномально высокое содержание электролитов. Показателями для постановки диагноза становятся, помимо анализа на муковисцидоз, кишечный синдром или бронхолегочный процесс, случаи заболевания в семье. Следует помнить, что иногда даже отрицательный результат анализа на муковисцидоз не гарантирует отсутствия данного заболевания на 100%.
Для диагностики также делают анализ крови, который, однако, чаще используют для определения вероятности рождения больного муковисцидозом ребенка у определенной супружеской пары, поскольку человек может не быть больным муковисцидозом, но быть его носителем. При определении носительства муковисцидоза обоими родителями существует двадцати пяти процентная вероятность рождения больного муковисцидозом ребенка. Поэтому в таких обстоятельствах, если супруги уже ждут ребенка, делается анализ плаценты плода на муковисцидоз, проводящийся на 11 неделе беременности. Если анализ будет положительным родители должны определиться стоит ли рожать или прерывать беременность.
Диагностика заболевания
Очень важно как можно раньше диагностировать это опасное заболевание, в таком случае прогноз намного благоприятнее, чем при несвоевременно поставленном диагнозе и начатом лечении. Для своевременной диагностики используются такие методы:
- Бронхоскопия – необходима для исследования консистенции образуемой мокроты.
- Развернутые анализы крови и мочи.
- Потовый тест. На сегодняшний день это самая информативная методика определения муковисцидоза;
- Бронхография – необходима для определения возникающих бронхоэктазов.
- Анализ ДНК, для определения мутирующего гена.
- Микробиологическое исследование отходящей мокроты.
- Спирометрия, для определения состояния легочной ткани.
- Рентген, для обнаружения изменений в бронхах и легких.
- Копрограмма, необходима для исследования количества жира, которое содержится в каловых массах.
По показаниям врача могут быть назначены и другие исследования, которые позволят уточнить диагноз, но обычно вышеперечисленных мероприятий хватает, чтобы диагностировать патологию.
При легочной и смешанной форме муковисцидоза главным методом диагностики считается бронхоскопия.
Диагностика муковисцидоза
Диагностика муковисцидоза начинается с самых корней: собирается информация обо всех семейных заболеваниях, были ли у родственников симптомы муковисцидоза, чем характеризовались, в какой степени проявлялись. Проводится генетическое исследование ДНК (в идеале — у будущих матерей) на наличие или отсутствие дефектного гена. При наличии такового будущие родители непременно должны быть предупреждены о возможных последствиях.
Для муковосцидоза разработан специальный потовой тест, который заключается в определении содержания натрий- и хлорид-ионов в поте пациента после предварительного введения пилокарпина. Последний стимулирует выработку слизи и пота железами внешней секреции. Предположить наличие муковисцидоза можно при концентрации хлора в поте пациента выше 60 ммоль/л.
После потового теста проводят лабораторные анализы мокроты, кала, крови, эндоскопическое исследование бронхов, спирографическое исследование, дуоденальное зондирование с взятием секрета поджелудочной железы и его дальнейшим исследованием на наличие активных ферментов.
Лечение
Муковисцидоз не поддается полноценному лечению, поэтому терапия только симптоматическая и направлена на восстановление дыхания и нормализацию функций важных органов. Так при разных формах болезни может быть показана такая терапия:
- Легочная форма. При таком течении болезни очень важно восстановить нормальное дыхание, а также предотвратить сопутствующие инфекции. В этом случае назначают муколитики и ферметивные препараты. Помимо этого рекомендована лечебная физкультура и щадящий массаж грудной клетки.
- Кишечная форма. В данном случае просто необходимо придерживаться рациона питания, в котором будет большое количество протеинов. Больные должны кушать много мясной продукции, рыбы, творога и яиц. В это же время потребление жиров и углеводов сокращают, для улучшения пищеварения могут быть назначены ферменты и витаминные препараты.
- Если патология осложнилась острым бронхитом или воспалением легких, то в терапию включают антибиотики. При тяжелом течении пневмонии могут быть назначены гормональные препараты.
- Чтобы поддержать работу сердечной мышцы часто прописывают метаболитики;
- Если эффект после прописанного лечения отсутствует, то показано промывание бронхов специальными растворами.
Муковисцидоз полностью не излечивается, поэтому многие медики схожи во мнении, что единственным выходом может быть пересадка легких. Однако в таком случае прогноз тоже не очень благоприятный, ведь больному придется постоянно принимать медикаменты, да и гарантии того, что пересаженный орган не отторгнется, никто не даст.
Диагностика и анамнез
Если у пациента наблюдается снижение веса, то заболевание характеризуется гипертрофией. Обычно происходит отставание пациента в физическом развитии. А также отмечаются заболевания бронхов, пазух носа, лёгких и формируется дыхательная недостаточность. Частым признаком муковисцидоза является панкреатит и диспептические жалобы. Чтобы точно выявить заболевание, проводятся лабораторные и клинические исследования. К ним причисляются:
- Молекулярный анализ.
- Взятие пота на определение количества хлорида натрия.
- Копрологическое исследование кала.
Первый тест, который проводится — это проба пота. Он отбирается трёхкратно, сбор жидкости проводится после провокативного электрофореза. Копрологические исследования делаются для установления химотрипсина в стуле. Если выявлена недостаточность поджелудочной железы, то анализ даст результат более 25 моль в сутки. Нахождение химотрипсина определяется с помощью разнообразных тестов.
Наиболее точным методом для определения заболевания является ДНК-диагностика. Сейчас она повсеместно используется врачами, но у этого метода есть несколько существенных недостатков: В малонаселенных регионах способ обычно бывает недоступен. У ДНК-диагностики высокая стоимость. А также врачами используется перинатальная диагностика. Чтобы выявить анамнез, берутся околоплодные воды. Проведение анализа возможно после 20 недель. Ошибочность результата колеблется в пределах не более 4%.
Лечебные мероприятия
Все действия для лечения заболевания носят симптоматический характер. Лечение муковисцидоза направлено на улучшение состояния пациента. Основное в терапии — это восстановление питательных элементов в желудочно-кишечном тракте. У пациентов бывает неполноценное пищеварение, поэтому их питание должно быть более витаминизированным и насыщенным на 30% больше, чем обычный рацион здорового человека.
Правильное питание
Основная диета — это потребление необходимого количества белков. Пациент должен в обязательном порядке включить в рацион мясные продукты, яйца, рыбу и творог. При этом нужно снизить потребление жирной пищи до минимума. Запрещается есть говядину и свинину, потому что мясо обладает тугоплавкими жирами. Недостаток жирных кислот компенсируется употреблением полиненасыщенных жирных соединений. Чтобы расщепить эти элементы, не нужен поджелудочный сок и липаза. Обычно именно в этих веществах организм больного испытывает недостаток.
Врачи рекомендуют свести к минимуму употребление лактозы и углеводов. Анализами устанавливается, какой именно недостаток сахарозы имеется у больного. Лактоза причисляется к молочному сахару, который обнаруживается в молочных продуктах. В поджелудочном соке больного обнаруживается дефицит фермента, который отвечает за расщепление пищи. Поэтому молочные продукты приведут к ухудшению пищеварения.
В летний период у человека усиливается потоотделение, соответственно, происходит дефицит хлорида натрия в организме. Его недостаток компенсируется добавлением вещества в пищу. У заболевшего муковисцидозом в каждодневном рационе должно присутствовать обильное питье, а также продукты, которые включают в себя витамины всех групп и полезные вещества. Нужно употреблять в необходимом количестве сливочное масло. А также в меню должны быть включены фрукты и овощи.
Из-за сбоев в пищеварительном процессе назначаются ферментные медикаменты, основой которых считается панкреатин. Доза лекарств определяется исходя из количества стула и определения нейтрального жира в кале.
Лечение легочных патологий
Для борьбы с заболеванием пациенту прописываются муколитики. Это специальные элементы, которые размягчают бронхиальную мокроту. Лечение должно проводиться на протяжении всей жизни пациента. Оно заключается не только в применении медицинских препаратов, но и в проведении физических процедур:
- Вибрационный массаж.
- Правильно подобранная физкультура.
- Ингаляции.
Бронхоскопия — это специальное мероприятие, которое позволяет эффективно бороться с муковисцидозом. Осуществляется промывка бронхиального дерева с применением физиологического раствора или муколитиков. Если у пациента выявлены респираторные заболевания, пневмония или бронхиальной отит, то для лечения понадобятся антибактериальные медикаменты. Основным симптомом является дефицит пищеварения. Поэтому антибиотики вводятся перорально с помощью аэрозолей или инъекции.
Основным лечебным мероприятием считается трансплантация легких. Это серьезная операция, вопрос о проведении мероприятия появляется в случае, когда терапия исчерпала свои возможности. Чтобы повысить качество жизни пациента, понадобится пересадка обоих легких.
Эта процедура поможет, если от заболевания не пострадали другие органы в организме. В противном случае серьёзное вмешательство не принесёт ожидаемого эффекта.
Методы лечения
Муковисцидоз (симптомы у взрослых появляются при развитии осложнений генетической патологии) лечится комплексными методами с целью устранения дискомфортных признаков заболевания, нарушений в работе пищеварительной и дыхательной системы.
Применяются медицинские препараты, также пациентам рекомендуется посещать физиотерапевтические процедуры, придерживаться диетического питания. Госпитализация показана в тяжелых ситуациях, когда впервые поставлен диагноз муковисцидоз или при обострении заболевания. То же самое касается тяжелой дыхательной недостаточности.
Лекарственные препараты
Комплексную терапию подбирает врач после полной медицинской диагностики. Неправильное лечение или самостоятельные действия могут спровоцировать серьезные осложнения.
| Группа лекарств | Название | Описание |
| Муколитики | Амброксол, Бромгексин | Лекарства разжижают слизь. Препараты рекомендуется принимать после еды, запивая небольшим количеством воды. Взрослая дозировка составляет 30 мг (1 таблетка) 2-3 раза в сутки. |
| Антибактериальные препараты | Азитромицин, Амоксициллин | Препараты уменьшают воспалительный процесс. Лекарство принимают 1 раз в сутки перед едой или после трапезы. Взрослая дозировка составляет 500 мг. Курс терапии продолжается 3 дня. |
| Ферменты | Панкреатит, Панцентрат | Лекарства поддерживают работу поджелудочной железы. Для каждого пациента подбирается индивидуальная дозировка и схема лечения. В среднем взрослым назначают по 150 000 ЕД в день. Курс лечения зависит от состояния человека, продолжается несколько дней или месяцев. |
| Противовоспалительные средства | Ибупрофен | Лекарство принимают внутрь после еды, запивая достаточным количеством воды. Взрослая дозировка зависит от интенсивности болевого синдрома, 400-800 мг 3 раза в день. |
| Противогрибковые препараты | Флуконазол, Вориконазол | Взрослая дозировка зависит от состояния человека, составляет 150-400 мг 1 раз в день. Курс лечения в среднем продолжается 1-2 недели. |
| Бронхолитики | Сальбутамол, Ипротропия | Препарат используется для ингаляций. Взрослым назначают по 1-2 ингаляции (100-200 мкг) до 4-х раз в сутки. |
У большей части пациентов при муковисцидозе наблюдается дефицит витаминов. Для их пополнения врач назначается комплексные препараты (Ретинол, Токоферол). При необходимости корректировать терапию и лечить сопутствующие заболевания может понадобиться дополнительная консультация пульмонолога, диетолога, гастроэнтеролога и физиотерапевта.
Народные методы
Муковисцидоз (симптомы у взрослых помогут врачу определить стадию развития заболевания и подобрать максимально эффективные средства) можно лечить рецептами знахарей и целителей, однако следует проводить комплексное лечение.
Применение рецептов также необходимо обсудить с лечащим врачом. Используемые компоненты могут спровоцировать аллергическую реакцию или усугубить состояние здоровья.
| Название | Рецепт | Применение |
| Ветки груши | Молодые отростки дерева измельчить и залить крутым кипятком (1 л). Полученную смесь поставить на огонь, довести до кипения и остудить. | Готовый отвар рекомендуется пить при муковисцидозе вместо чая. |
| Травяной сбор | Смешать одинаковыми частями девясил, одуванчик, пырей ползучий. Залить 2 ст.л. травяного сбора горячей водой (250 мл), оставить на 30 мин и процедить. | Готовое лекарство позволяет улучшить работу поджелудочной железы. |
| Ржаная лепешка на спину или грудь | Муку, мед и сливочное масло смешать с горчицей (0,5 ч.л.). Замесить плотное тесто. | Лепешку выложить на грудь и спину в области бронхов, накрыть пищевой пленкой и укутать шерстяным платком. Процедуру рекомендуется проводить на ночь. |
Справиться с кашлем помогает настойка прополиса, чай с лимоном и медом, цветочная пыльца. Грудную клетку и спину рекомендуется растирать барсучьим жиром для разжижения и выведения большого количества мокроты. Молоко с козьим жиром также уменьшает бронхоспазмы.
Прочие методы
Муковисцидоз (симптомы у взрослых требуют полной медицинской диагностики и правильно подобранного лечения) в комплексной терапии предусматривает соблюдение строгого диетического питания:
| Рекомендуемые продукты | Запрещенные продукты |
|
|
Пациентам с муковисцидозом рекомендуется больше пить жидкости, особенно в жаркий период времени, чтобы предупредить обезвоживание организма. Питаться необходимо маленькими порциями, но часто.
Комплексное лечение муковисцидоза предусматривает физиотерапевтические процедуры, которые улучшают состояние пациента и устраняют симптомы патологических процессов:
| Название | Описание |
| Ингаляции с небулайзером | Процедуры помогают удалить вязкую мокроту и расширяют бронхи. Лекарства попадают непосредственно в воспалительный очаг. Бронхорасширяющие препараты, которые оказывают дренирующее и антибактериальное действие, подбирает врач |
| Вибрационный массаж | Точечное воздействие помогает лучше отходить мокроте во время кашля. Улучшается также кровообращение. |
| Постуральный дренаж | Помогает очистить дыхательные органы от скопления большого количества слизи. Вместе с мокротой из организма больного выходят патогенные микроорганизмы, в результате чего уменьшаются симптомы интоксикации. Для проведения процедуры можно воспользоваться услугами пульмонолога или использовать специальный надувной грудной жилет. Он вибрирует с высокой частотой, что позволяет избавиться от густой слизи, которая накапливается в бронхах. |
| Лечебная физкультура | Спортивная гимнастика положительно влияет на функционирование системы кровообращения. Пациентам рекомендуется заниматься фитнесом, легкой атлетикой, танцами. |
| Кинезитерапия | Пациентам подбирается специальный комплекс дыхательных упражнений. Регулярные занятия разжижают и выводят мокроту из бронхов, устраняют воспалительный процесс. |
Радикальным методом лечения муковисцидоза у взрослых является пересадка легких.
Хирургическое лечение показано в том случае, если медикаментозная терапия не помогает компенсировать работу пораженных систем:
- пневмоторакс;
- усиленное кровохарканье, присутствующее постоянно или повторяющееся периодически;
- образование носовых полипов;
- развитие стойкого и хронического синусита;
- выпадение прямой кишки.
Операция также поможет исправить ситуацию, если муковисцидоз не повлиял на функционирование других внутренних органов человеческого организма.
Симптомы
У взрослых муковисцидоз может проявляться очень по разному, но чаще включает некоторые из следующих симптомов и признаков:
- постоянный кашель;
- хрипы при дыхании;
- инфекции легких (приблизительно 70% взрослых с муковисцидозом имеют в дыхательных путях синегнойную палочку – Pseudomonas aeruginosa);
- панкреатит (воспаление поджелудочной железы);
- синусит;
- недоедание;
- бесплодие (более 95% мужчин с заболеванием);
- артрит.
Также дополнительными признаками могут служить:
- бронхоэктатические болезни – заболевания, при которых происходит повреждение бронхов и нагноение;
- симптом барабанных палочек – утолщаются последние фаланги пальцев;
- полипы в носу;
- обструкция кишечника;
- билиарный цирроз печени.
Генетические причины
Муковисцидоз у детей вызывается дефектным геном, контролирующим поглощение соли организмом. При заболевании в клетки организма поступает слишком много соли и недостаточно воды.
Это превращает жидкости, которые обычно «смазывают» наши органы, в густую липкую слизь. Эта слизь блокирует дыхательные пути в лёгких и закупоривает просветы пищеварительных желёз.
Главным фактором риска развития муковисцидоза является семейная история болезни, особенно если кто-то из родителей является носителем. Ген, вызывающий муковисцидоз, рецессивен.
Это значит, что для того, чтобы иметь это заболевание, дети должны наследовать две копии гена, по одному от мамы и папы. Когда ребёнок наследует только одну копию, у него не развивается муковисцидоз. Но этот малыш по-прежнему будет носителем и может передать ген своему потомству.
Родители, несущие ген муковисцидоза, часто здоровы и не имеют симптомов болезни, но передадут ген своим детям.
На самом деле, по разным оценкам, до 10 миллионов человек могут являться носителями муковисцидозного гена и не знать об этом. Если у мамы и папы имеется дефектный ген муковисцидоза, то у них с вероятностью 1:4 может родиться ребёнок с муковисцидозом.
Причины появления
Основная причина генетического заболевания – это нарушение процесса выработки слизистого секрета внутренними органами человеческого организма в результате мутации гена (трансмембранного регулятора муковисцидоза).
Он поддерживает обмен эпителиальных тканей, которые выстилают пищеварительный тракт, поджелудочную железу, печень, репродуктивные и бронхолегочные органы. Заболевание в большинстве случаев поражает легкие или органы пищеварительной системы.
Мутирующий ген нарушает структуру синтезируемого белка. Он становится густым и вязким. Застаивание слизи сопровождается повышением в ней уровня хлора и натрия. Патологические процессы приводят к уменьшению в размерах желез эпителия. Происходит распространение соединительной ткани.
Существуют также провоцирующие факторы, на фоне которых повышается риск развития осложнений генетического заболевания:
- неблагоприятная окружающая обстановка;
- респираторные аллергические факторы;
- вредные привычки (табачные изделия, спиртные напитки).
Скапливающаяся слизь создает благоприятные условия для развития патогенных микроорганизмов, что приводит к резкому развитию многочисленных заболеваний и появлению гнойных осложнений.